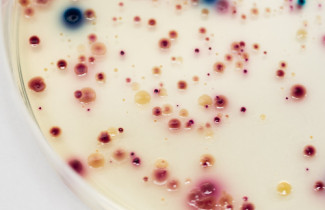
Tutkimusryhmän kuva: Vesihygienia

Seminaari Euroopan ja Suomen vesien tilasta kokosi monialaisesti yhteen tutkijoita ja europarlamentaarikkoja.
EU:n vesilainsäädäntöä päivityksen kohteina ovat vesipuite-, pohjavesi- ja ympäristönlaatunormidirektiivit. EU-komissio on esittänyt vesidirektiivien piiriin PFAS-yhdisteitä eli niin sanottuja ikuisuuskemikaaleja sekä joitakin lääkeaineita. Uusien yhdisteiden vaikutuksia tai yhteisvaikutuksia ihmiseen ja luonnon monimuotoisuuteen ei vielä tunneta.
Itä-Suomen yliopiston UEF Water -tutkimusyhteisö ja Euroopan parlamentin vihreiden ryhmä järjestivät Puhtaat vedet – saavuttamaton unelma? -seminaarin Itä-Suomen yliopiston Kuopion kampuksella 22.5.2023. EU-direktiivien päivityksestä, Suomen vesien tilasta ja lisätutkimuksen tarpeista keskustelivat toimittaja Juha Kauppisen johdolla Euroopan parlamentin jäsenet Elsi Katainen (kesk) ja Ville Niinistö (vihr), ympäristöministeriön edustajana ympäristöneuvos Juhani Gustafsson sekä Itä-Suomen yliopiston professorit Jussi Kukkonen ja Anssi Vainikka ja väitöskirjatutkija Suvi-Tuuli Puharinen. Tilaisuuteen osallistui myös 50 ihmistä paikalla tai etäyhteyden välityksellä.
Jussi Kukkonen korosti lisätutkimuksen tarvetta erityisesti uusien biologisten, kustannustehokkaiden menetelmien kehittämiseksi. Lisäksi tuotekehittelyn tai prosessisuunnittelun alkuvaiheessa tulisi tarkastellaan haitta-aineiden ympäristöön pääsyn estämistä ja potentiaalisia vaikutuksia.
Anssi Vainikka painotti ekosysteemilähestymistavan käyttöä kaikessa vesienhoidossa. Kalasto ja vedenlaatu ovat sidoksissa toisiinsa ja useat uhanalaiset lajit ovat riippuvaisia hyvästä vedenlaadusta. Hävinneitä lajeja on vaikeaa palauttaa.
Suvi-Tuuli Puharisen mukaan ympäristölainsäädäntö asettaa kunnianhimoisia tavoitteita vesien tilalle, mutta tarvittavat oikeudelliset keinot puuttuvat vielä osin. Tulevaisuudessa on kiinnitettävä huomiota muihin yhteiskunnan toimintoja ohjaaviin oikeudenaloihin ja varmistettava ympäristönäkökohtien integrointi niihin entistä läheisemmin.

Europarlamentaarikko Elsi Katainen korosti puhtaan veden merkitystä ruokaturvan ja huoltovarmuuden näkökulmasta – puhdas juoma- tai kasteluvesi ei ole itsestäänselvyys.
Europarlamentaarikko Ville Niinistön mukaan kysymys on siitä, ovatko pinta- ja pohjavetemme turvallisia ja puhtaita, ja tarjoavatko ne hyvän elinympäristön monimuotoiselle vesistöluonnolle. Pinnan alle on piilotettu ympäristöongelmia liian pitkään. Suomalaista huippututkimusta aiheesta tarvitaan. Siihen nähden, kuinka rakkaita vesistömme ovat suomalaisille, on niiden suojelu ja tilan vaaliminen on huonosti priorisoitua, muistutti Niinistö.
Lue myös Euroopan parlamentin vihreiden ryhmä tiedote seminaarista.
Lisätietoja
Hannu Nykänen, UEF Water -tutkimusyhteisön koordinaattori, yliopistotutkija, ympäristö- ja biotieteiden laitos, Itä-Suomen yliopisto, [email protected]